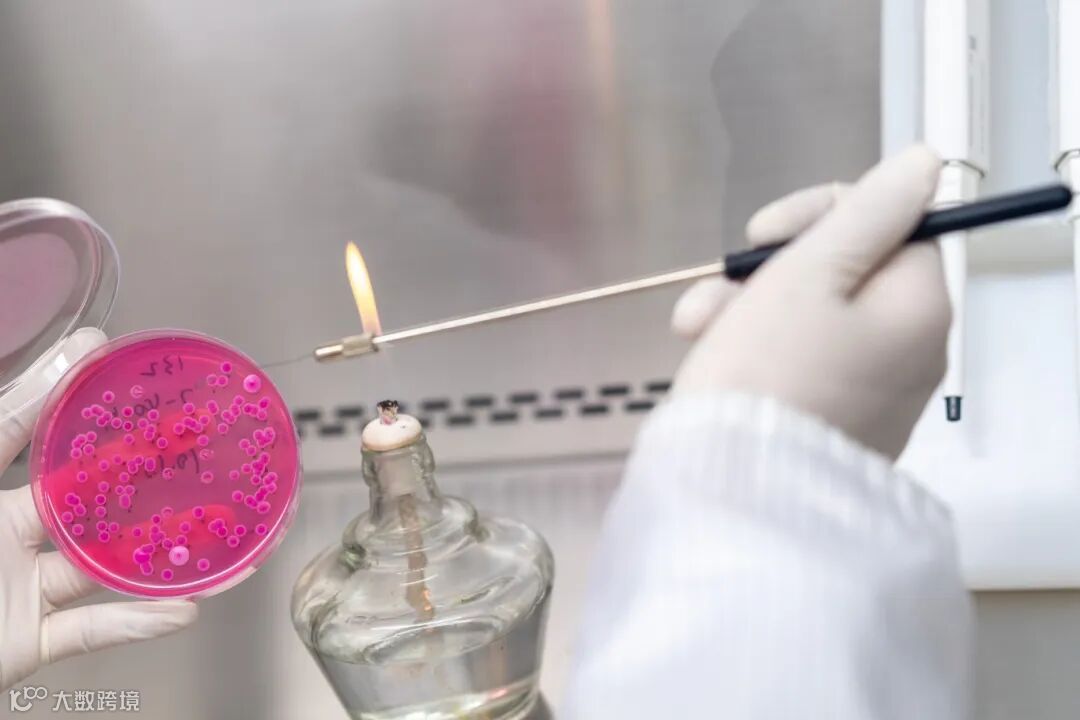
GPS02066(1).JPG

国内生物科技领军企业路德生物环保科技股份有限公司(以下简称“路德科技”),为深化合成生物学战略布局,公司正式在浙江省杭州市萧山区设立全资子公司——路康德生物科技(杭州)有限公司。新公司注册资本3000万元人民币,将聚焦动物营养、未来食品、医美原料三大方向,构建覆盖研发、中试及产业化的合成生物学创新平台。
战略升级:
抢占合成生物学
赛道制高点
此次布局标志着路德科技从传统生物环保领域向前沿生物制造的战略跃迁。杭州作为长三角核心城市,拥有互联网、人工智能与生物医药深度融合的产业生态,叠加萧山区“生物制造先导区”的政策红利,为路德科技提供了技术迭代与人才集聚的双重优势。新公司将依托长三角市场与供应链资源,通过“杭州研发+区域协同”模式,打造公司第二增长曲线。
业务聚焦:
三大赛道锚定
高附加值领域

新设立的杭州子公司将重点突破以下领域:
动物营养:开发新型饲料添加剂与功能性蛋白,助力养殖业提质增效;
未来食品:探索细胞培养蛋白、功能性食品成分等创新产品;
医美原料:研发绿色合成活性成分,切入化妆品与保健品上游供应链。
公司计划通过“自主研发+联合开发”双轮驱动,联合高校、科研机构共建研发平台,并灵活采用本地生产或委托加工模式,提高技术转化效率。
区域协同:
深度融入
长三角创新网络
杭州萧山区作为浙江省生物经济核心区,已集聚一批顶尖科研平台与产业链企业。路德科技此次落子,将直接对接杭州的数字化技术优势与长三角一体化市场资源。新公司注册地址位于萧山生命科学科创中心,周边覆盖生物医药企业集群与高端人才社区,有望形成“技术-人才-市场”闭环生态。
路德科技董事长季光明表示:“合成生物学是颠覆传统生产方式的战略性赛道。杭州子公司的成立,是公司拥抱科技革命、优化全国布局的关键一步。我们将以杭州为支点,整合长三角创新资源,打造具有行业影响力的生物制造标杆。”
编辑:李佳薇
审核:周雅凡


